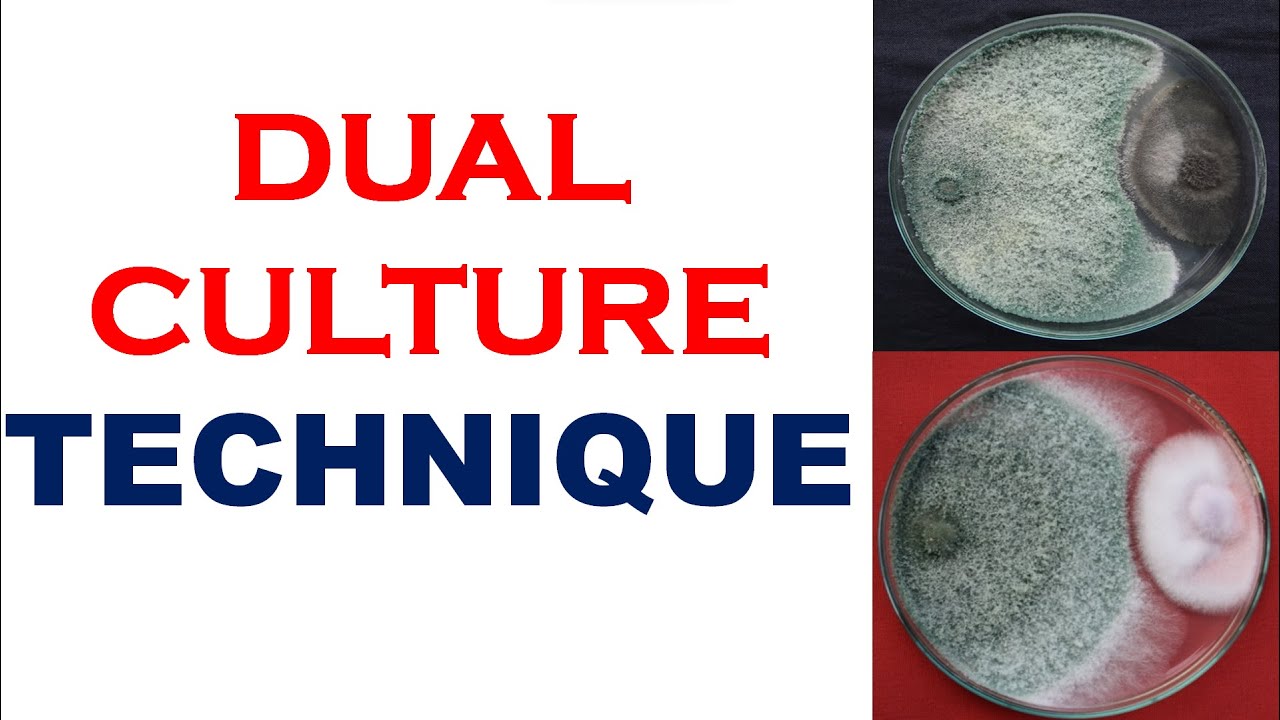
Dual Culture Technique

Seed Health Test | Seed Science #59 | ICAR JRF and CUET Preparation | Prayas | By Meenakshi Mam скачать в хорошем качестве
Повторяем попытку...

Скачать видео с ютуб по ссылке или смотреть без блокировок на сайте: Seed Health Test | Seed Science #59 | ICAR JRF and CUET Preparation | Prayas | By Meenakshi Mam в качестве 4k
У нас вы можете посмотреть бесплатно Seed Health Test | Seed Science #59 | ICAR JRF and CUET Preparation | Prayas | By Meenakshi Mam или скачать в максимальном доступном качестве, видео которое было загружено на ютуб. Для загрузки выберите вариант из формы ниже:
-
Информация по загрузке:
Скачать mp3 с ютуба отдельным файлом. Бесплатный рингтон Seed Health Test | Seed Science #59 | ICAR JRF and CUET Preparation | Prayas | By Meenakshi Mam в формате MP3:
Если кнопки скачивания не
загрузились
НАЖМИТЕ ЗДЕСЬ или обновите страницу
Если возникают проблемы со скачиванием видео, пожалуйста напишите в поддержку по адресу внизу
страницы.
Спасибо за использование сервиса ClipSaver.ru
Seed Health Test | Seed Science #59 | ICAR JRF and CUET Preparation | Prayas | By Meenakshi Mam
In this detailed video, we'll discuss the Seed Health Test in Seed Science. Seed Health Test in Seed Science for ICAR JRF and CUET Exam by Dr. Meenakshi Rathi. Subscribe to Agriculture Adda247 for the best guidance and preparation for the exams. #SeedHealth #SeedScience #AgricultureExam #ICARJRF #ICARJRFGenetics 🔴 Check Out our Courses: 👉 Agriculture MahaPack: https://adda247.app.link/AGRICULTUREM... 👉IBPS SO AFO yoddha pre+ Mains -https://adda247.app.link/IBPS_AFO_YOD... 👉IBPS SO AFO yoddha Mains -https://adda247.app.link/IBPS_AFO_YOD... 👉FSSAI ASSISTANT RE-EXAM : https://adda247.app.link/Fssai_assist... 👉IFFCO AGT 2023 :https://adda247.app.link/IFFCO_AGT_29Sep 👉CWC:- https://adda247.app.link/CWC_13_OCT 👉Nabard:- https://adda247.app.link/Nabard_Grade... 👉 UPSSSC AGTA: https://adda247.app.link/Upsssc_Agta_... 👉RAJASTHAN Supervisor:-https://adda247.app.link/Rajasthan_Su... 👉JHARKHAND FSO:- https://adda247.app.link/JPSC_FSO_17_OCT 👉FSSAI CFSO,TO :- https://adda247.app.link/FSSAI_CFSO_T... 👉Chhattisgrah RAEO:- https://adda247.app.link/CG_RAEO_29SEP 👉WBPSC ADA:- https://adda247.app.link/WBPSC_ADA_26SEP 👉UKSSSC AAO:- https://adda247.app.link/UKSSSC_AAO_2... 👉OPSC AAO BATCH: https://adda247.app.link/OPSC_AAO_12SEP 👉 UPCATET Batch: https://adda247.app.link/UPCATET11JULY 👉 MSC Entrance: https://adda247.app.link/MSCENTRANCE1... 🔴 Check Out our BOOKS: 👉THE AGRI PULSE CURRENT AFFAIRS BOOK-: https://adda247.app.link/PULSE_AGRI 👉 ACE Agriculture Printed Book (Vol 1 & 2): https://adda247.app.link/ACEAGRICULTU... 🔴 Download our Adda247 App: https://adda247.app.link/Meenakshi_Rathi 🔴 Aiming for Agriculture Govt. Exams 2022? Get Counselling from Team Adda247 : https://bit.ly/3rT7EAD 🔴 Join Agriculture Adda247 Telegram Channel :- https://t.me/agricultureclassadda247 Welcome to Agriculture Adda247 - The Best Agricultural Exams Preparation Channel. Prepare for AFO - Bank of Maharashtra, IBPS AFO, FSSAI, State Agricultural Exams (Haryana PSC - ADO, SDAO, UKSSC AAO, UPPSC, RSMSSB ) FCI, NABARD, NSC, IFFCO-AGT, CCI, CWC, NFL and a Lot More. 🔴 Agriculture Adda247 Live Classes Schedule:- 👉 9:00 AM- बिना PPT वाली क्लास By Krashna Sir 👉10:00 AM - 10:30 AM - Agriculture Current Affairs Class By Sandeep Sir 👉10:30 AM - 11:00 AM - Sankalp - General Agriculture Class By Sandeep Sir 👉11:00 AM - 11:30 AM - Hindi wali Class (UPSSSC AGTA & Rajasthan Supervisor) 👉11:30 AM - 12:00 PM - NABARD Grade A ARD Class 👉12:00 PM - 1:00 PM - Arjun 👉1:00PM - 1:30PM Cotton Corporation Of India 👉1:30PM - 2:00PM FSSAI ASSISTANT RE-EXAM 👉2:00PM - 3:00PM Junoon 👉4:00 PM - 5:00 PM - Manthan Class by Sudhanshu Sir 👉6:00 PM - 7:00 PM - Udaan Class By Pratibha Ma'am 👉8:00 PM - 8:30 PM - Aagaaz Class By Akash Sir 👉8:30 PM - 9:00 PM - IBPS AFO Success Mantra Horticulture By Akash Sir 🔴 What This Channel is All About? ❖Daily Conceptual Classes For All Agricultural Competitive Exams Preparation ❖Daily MCQ sessions For All Agricultural Competitive Exams Preparation ❖Agricultural Current Affair Update For All Agricultural Competitive Exams Preparation ❖ Latest Agricultural Exams Notification With Detailed Full Information ❖ Agricultural Exam Preparation Tips and Best Strategies To Crack Any Agriculture Exam in First Attempt ❖ Best Agricultural Exams Analysis ❖ Best Test Series and Online Courses for Agricultural Exams ❖ Connect With Other Aspirants With Success Stories ❖ Classes in Both Hindi and English Medium #AgricultureAdda247 #AgricultureAdda